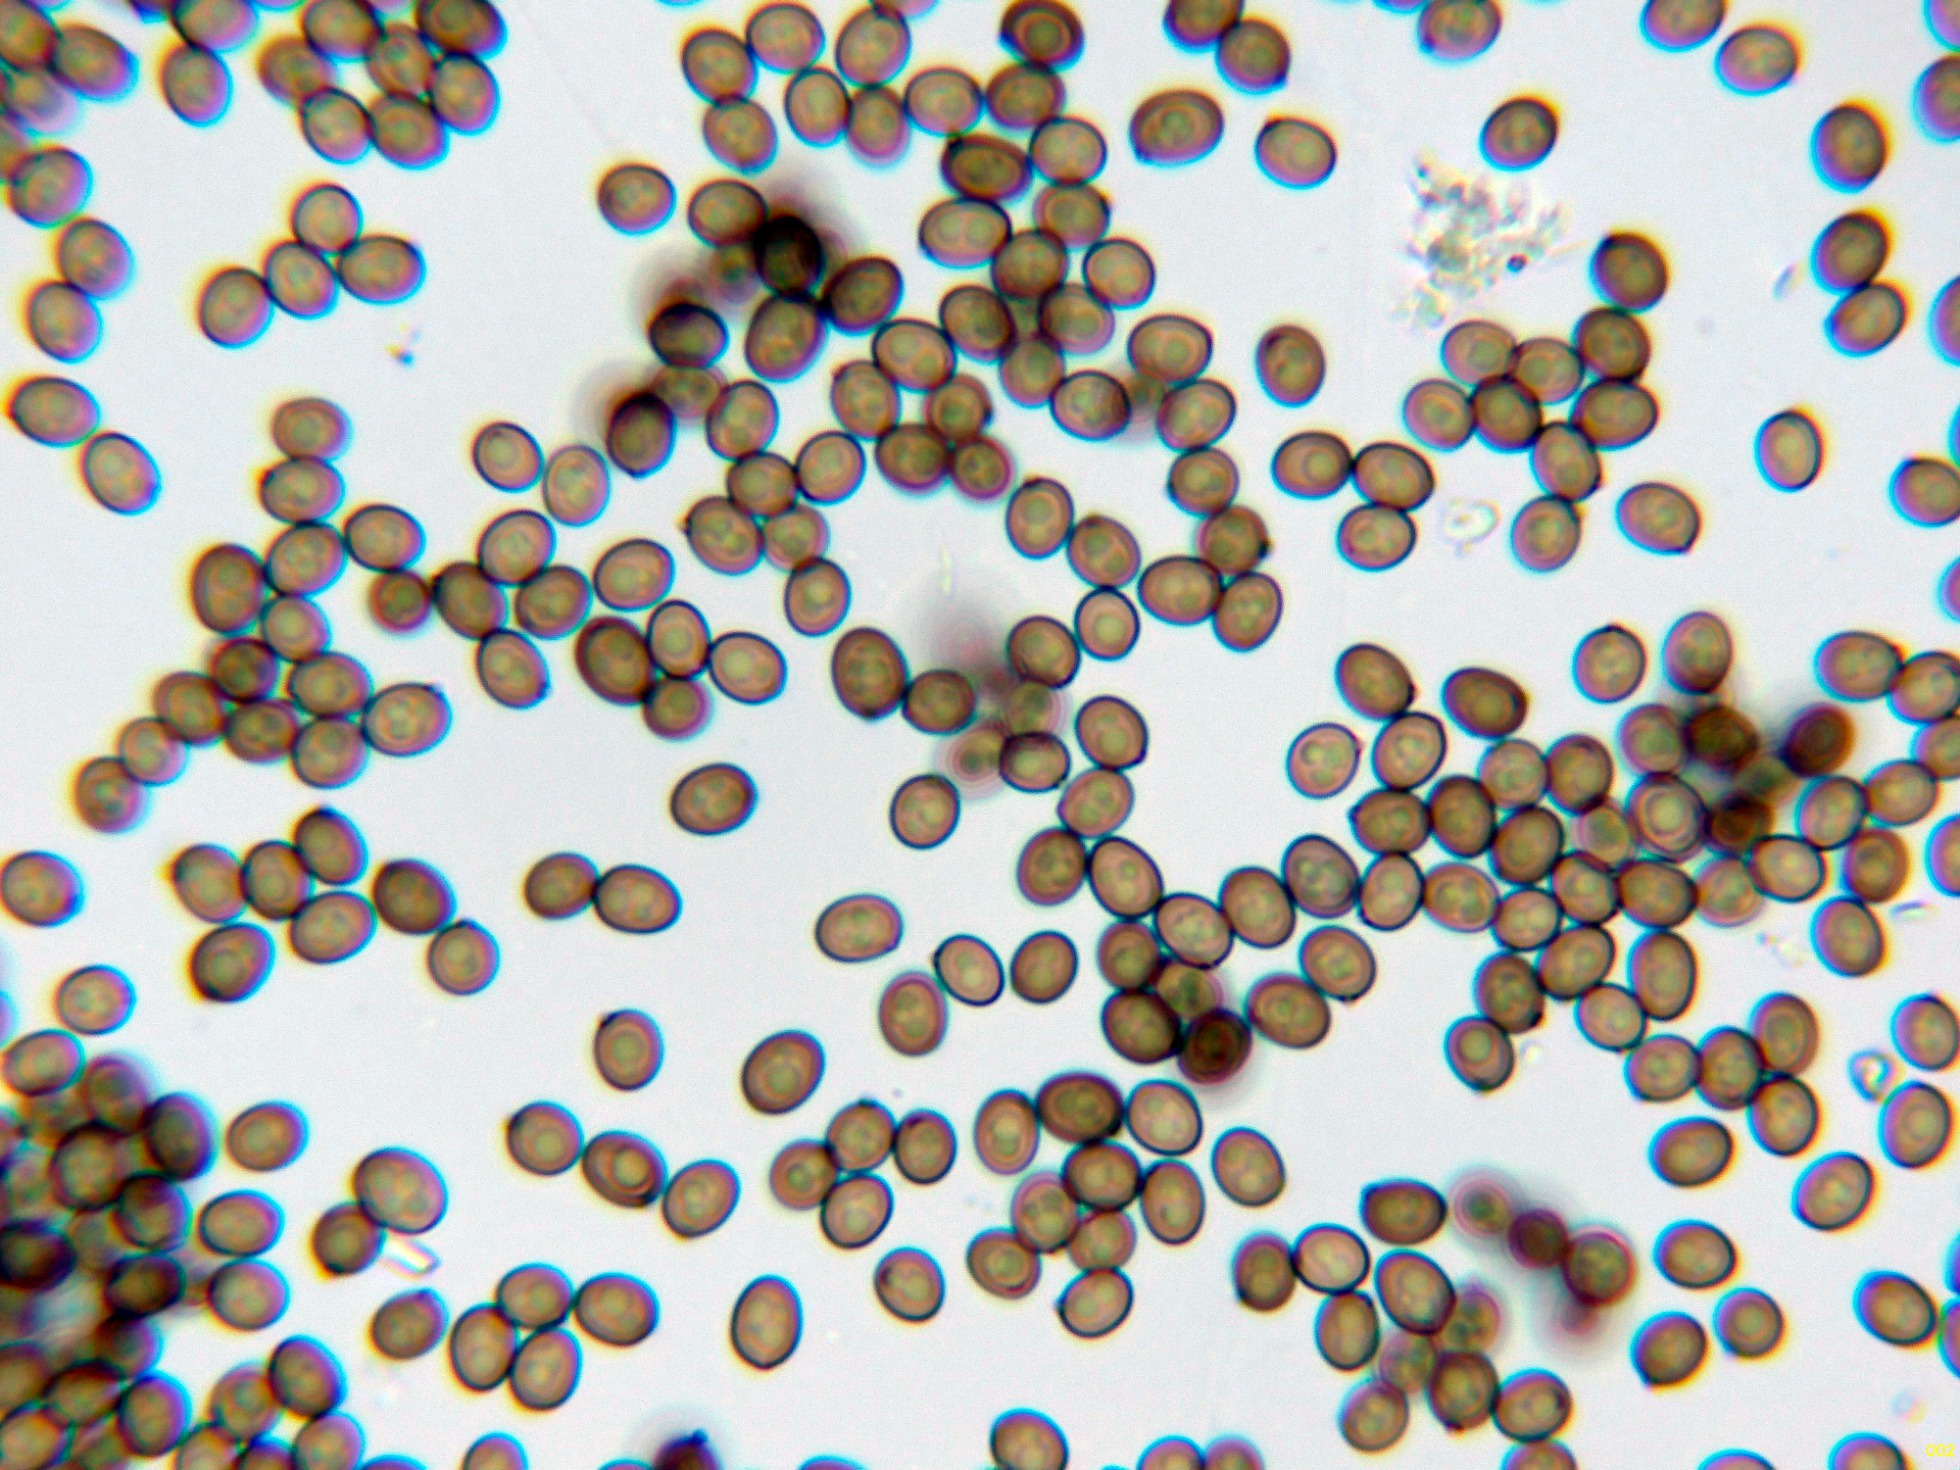
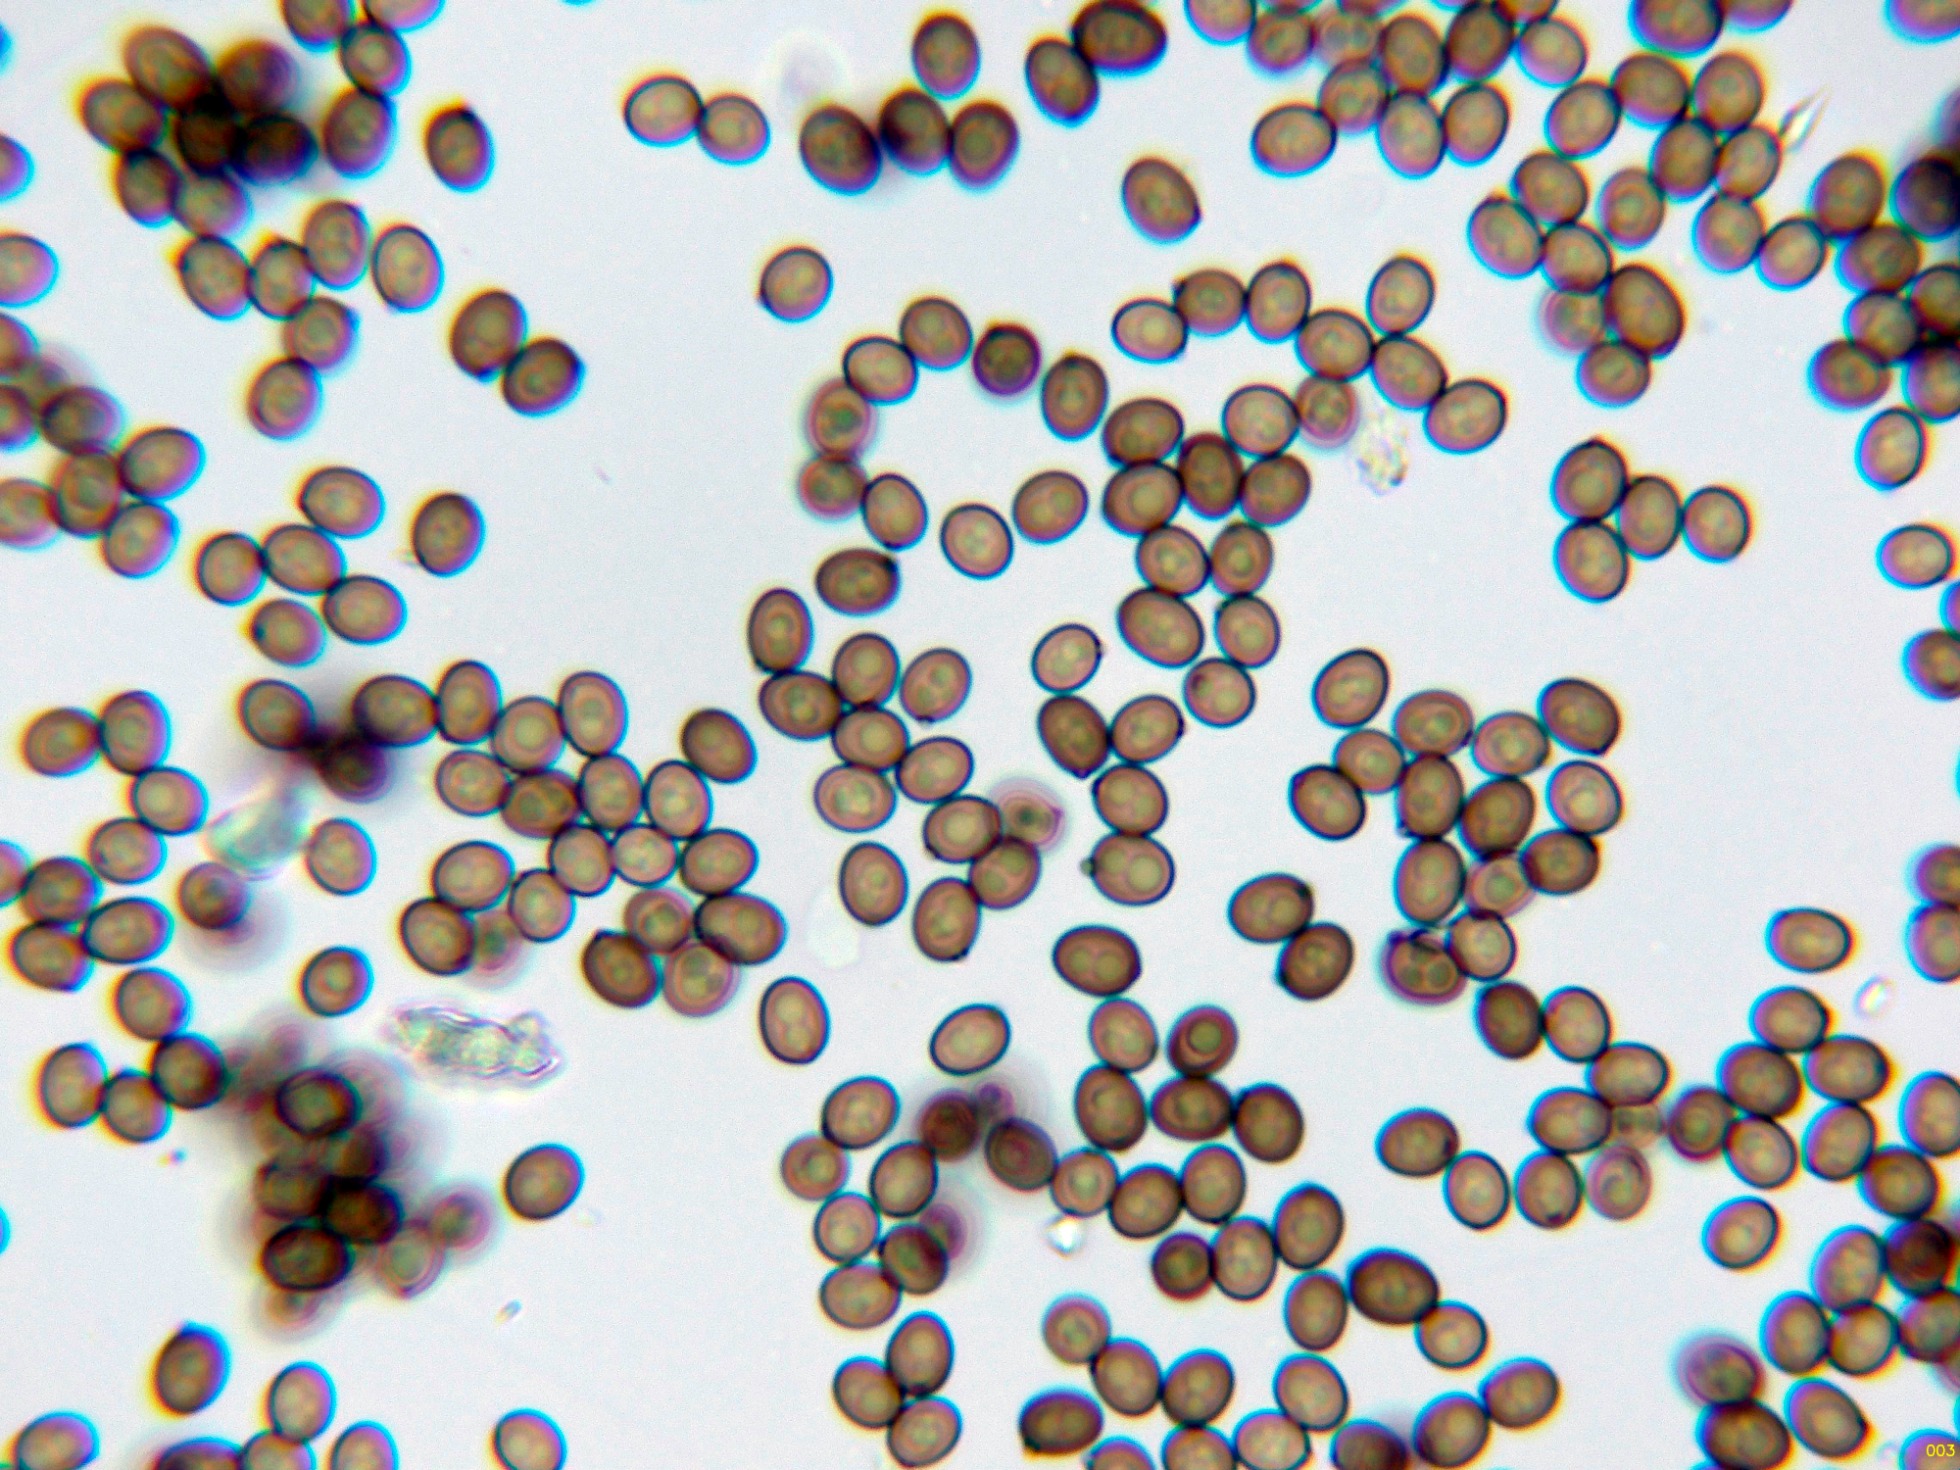

Media docena más del domingo 19 de mayo.
Media docena más del domingo 19 de mayo.
- Josep Torres
-
 Autor del tema
Autor del tema
- Fuera de línea
- Moderador
-

Menos
Más
- Mensajes: 8746
- Gracias recibidas: 8379
1 año 9 meses antes #110000
por Josep Torres
Media docena más del domingo 19 de mayo. Publicado por Josep Torres
Hola a tod@s.
Seis hongos más de la recogida de muestras del domingo 19 de mayo, una jornada muy fructífera, todas las mostradas localizadas en campa o bajo Pinus sylvestris, y que ya había estudiado en ocasiones anteriores.
Un Agaricus de campa de altura, ligeramente amarilleante con la manipulación, el Agaricus arvensis.
Hifas de la suprapellis en agua.
Arista laminar con queilocistidios no muy distintos de los basidios o basidiolos, con unas medidas de (17.3) 18.8 - 24.5 (25.7) × 5.9 - 8 (8.5) µm.
Los basidios de la cara laminar, tetraspóricos.
Y las esporas obtenidas por esporulación natural y en agua.
Estas esporas con unas medidas de:
(5.3) 5.6 - 6.5 (7.4) × (4.2) 4.3 - 5 (5.3) µm
Q = (1.2) 1.23 - 1.4 (1.5) ; N = 40
Me = 6.1 × 4.7 µm ; Qe = 1.3
Un Entoloma primaveral que micorriza con espinos, bajo Crataegus monogyna, el Entoloma clypeatum.
Las hifas de la suprapellis en agua.
Y por debajo de las anteriores, las hifas de la subpellis en agua, prácticamente idénticas a las de la suprapellis.
Arista laminar sin elementos diferenciados de los basidios.
Los basidios bisporicos y tetraspóricos.
Y las esporas obtenidas por esporulación natural y en agua.
Estas esporas con unas medidas de:
(8.1) 8.6 - 10.3 (10.8) × (7.3) 7.6 - 8.9 (9.6) µm
Q = (1) 1.1 - 1.2 (1.3) ; N = 32
Me = 9.5 × 8.2 µm ; Qe = 1.2
Un Corticial, por los datos microscópicos obtenidos, todo parece apuntar a la Efibulella deflectens.
Borde de crecimiento a 20 aumentos.
Las hifas subiculares, tal y como nos sugiere su nombre, sin fíbulas.
Los cistidios.
El himenio y los basidios.
No conseguí obtener esporas por medio de la esporulación natural, por lo que me tuve que contentar con las esporas libres en las muestras.
Una composición de estas esporas libres.
Estas esporas libres con unas medidas de:
(4.8) 4.9 - 5.7 (6) × (2.4) 2.45 - 2.9 (3.2) µm
Q = (1.7) 1.74 - 2.08 (2.1) ; N = 20
Me = 5.1 × 2.7 µm ; Qe = 1.9
Un Corticial Meruloide, segunda vez que me lo encuentro, muy parecido a la Leucogyrophana mollusca, pero con esporas muy diminutas y una microscopía completamente distinta, el Pseudomerulius aureus.
Un par de imágenes a 20 aumentos.
Las hifas subiculares en solución de Rojo Congo diluido.
Los basidios.
Un basidio con sus 4 esterigmas, tetraspórico.
Y las esporas.
Estas esporas con unas medidas de:
(3.3) 3.5 - 4.3 (4.6) × (1.7) 1.73 - 2 (2.1) µm
Q = (1.8) 1.9 - 2.4 (2.5) ; N = 30
Me = 3.9 × 1.9 µm ; Qe = 2.1
Un Lophodermium que presenté no hace mucho, dejo el enlace:
www.fungipedia.org/setas-informacion-y-c...roscopia.html#109900
En aquel estudio me lamentaba de que los ascomas estaban cerrados y que tardaron mucho en abrirse, ahora los he encontrado ya abiertos , el Lophoderrmium foliicola.
Un par de imágenes de los ascomas a 20 aumentos.
Con esta no me molesté en sacar la micoscopía de nuevo.
Y ya para terminar y sin microscopía, una que aunque parecía brotar del suelo, sin duda debía hacerlo sobre madera o raíces enterradas, el Polyporus arcularius, actualmente Lentinus arcularius.
Saludos a tod@s.
Seis hongos más de la recogida de muestras del domingo 19 de mayo, una jornada muy fructífera, todas las mostradas localizadas en campa o bajo Pinus sylvestris, y que ya había estudiado en ocasiones anteriores.
Un Agaricus de campa de altura, ligeramente amarilleante con la manipulación, el Agaricus arvensis.
Hifas de la suprapellis en agua.
Arista laminar con queilocistidios no muy distintos de los basidios o basidiolos, con unas medidas de (17.3) 18.8 - 24.5 (25.7) × 5.9 - 8 (8.5) µm.
Los basidios de la cara laminar, tetraspóricos.
Y las esporas obtenidas por esporulación natural y en agua.
Estas esporas con unas medidas de:
(5.3) 5.6 - 6.5 (7.4) × (4.2) 4.3 - 5 (5.3) µm
Q = (1.2) 1.23 - 1.4 (1.5) ; N = 40
Me = 6.1 × 4.7 µm ; Qe = 1.3
Un Entoloma primaveral que micorriza con espinos, bajo Crataegus monogyna, el Entoloma clypeatum.
Las hifas de la suprapellis en agua.
Y por debajo de las anteriores, las hifas de la subpellis en agua, prácticamente idénticas a las de la suprapellis.
Arista laminar sin elementos diferenciados de los basidios.
Los basidios bisporicos y tetraspóricos.
Y las esporas obtenidas por esporulación natural y en agua.
Estas esporas con unas medidas de:
(8.1) 8.6 - 10.3 (10.8) × (7.3) 7.6 - 8.9 (9.6) µm
Q = (1) 1.1 - 1.2 (1.3) ; N = 32
Me = 9.5 × 8.2 µm ; Qe = 1.2
Un Corticial, por los datos microscópicos obtenidos, todo parece apuntar a la Efibulella deflectens.
Borde de crecimiento a 20 aumentos.
Las hifas subiculares, tal y como nos sugiere su nombre, sin fíbulas.
Los cistidios.
El himenio y los basidios.
No conseguí obtener esporas por medio de la esporulación natural, por lo que me tuve que contentar con las esporas libres en las muestras.
Una composición de estas esporas libres.
Estas esporas libres con unas medidas de:
(4.8) 4.9 - 5.7 (6) × (2.4) 2.45 - 2.9 (3.2) µm
Q = (1.7) 1.74 - 2.08 (2.1) ; N = 20
Me = 5.1 × 2.7 µm ; Qe = 1.9
Un Corticial Meruloide, segunda vez que me lo encuentro, muy parecido a la Leucogyrophana mollusca, pero con esporas muy diminutas y una microscopía completamente distinta, el Pseudomerulius aureus.
Un par de imágenes a 20 aumentos.
Las hifas subiculares en solución de Rojo Congo diluido.
Los basidios.
Un basidio con sus 4 esterigmas, tetraspórico.
Y las esporas.
Estas esporas con unas medidas de:
(3.3) 3.5 - 4.3 (4.6) × (1.7) 1.73 - 2 (2.1) µm
Q = (1.8) 1.9 - 2.4 (2.5) ; N = 30
Me = 3.9 × 1.9 µm ; Qe = 2.1
Un Lophodermium que presenté no hace mucho, dejo el enlace:
www.fungipedia.org/setas-informacion-y-c...roscopia.html#109900
En aquel estudio me lamentaba de que los ascomas estaban cerrados y que tardaron mucho en abrirse, ahora los he encontrado ya abiertos , el Lophoderrmium foliicola.
Un par de imágenes de los ascomas a 20 aumentos.
Con esta no me molesté en sacar la micoscopía de nuevo.
Y ya para terminar y sin microscopía, una que aunque parecía brotar del suelo, sin duda debía hacerlo sobre madera o raíces enterradas, el Polyporus arcularius, actualmente Lentinus arcularius.
Saludos a tod@s.
Adjuntos:
El siguiente usuario dijo gracias: Juan Andrés Román
Por favor, Identificarse para unirse a la conversación.
- Juan Andrés Román
-

- Fuera de línea
- Spammer
-

Menos
Más
- Mensajes: 2558
- Gracias recibidas: 2756
1 año 9 meses antes #110008
por Juan Andrés Román
Respuesta de Juan Andrés Román sobre el tema Media docena más del domingo 19 de mayo.
Buen aporte el de estas especies Josep............................ Saludos.
El siguiente usuario dijo gracias: Josep Torres
Por favor, Identificarse para unirse a la conversación.
- Josep Torres
-
 Autor del tema
Autor del tema
- Fuera de línea
- Moderador
-

Menos
Más
- Mensajes: 8746
- Gracias recibidas: 8379
1 año 9 meses antes #110014
por Josep Torres
Respuesta de Josep Torres sobre el tema Media docena más del domingo 19 de mayo.
El siguiente usuario dijo gracias: Juan Andrés Román
Por favor, Identificarse para unirse a la conversación.
Tiempo de carga de la página: 0.414 segundos

Foro de micología